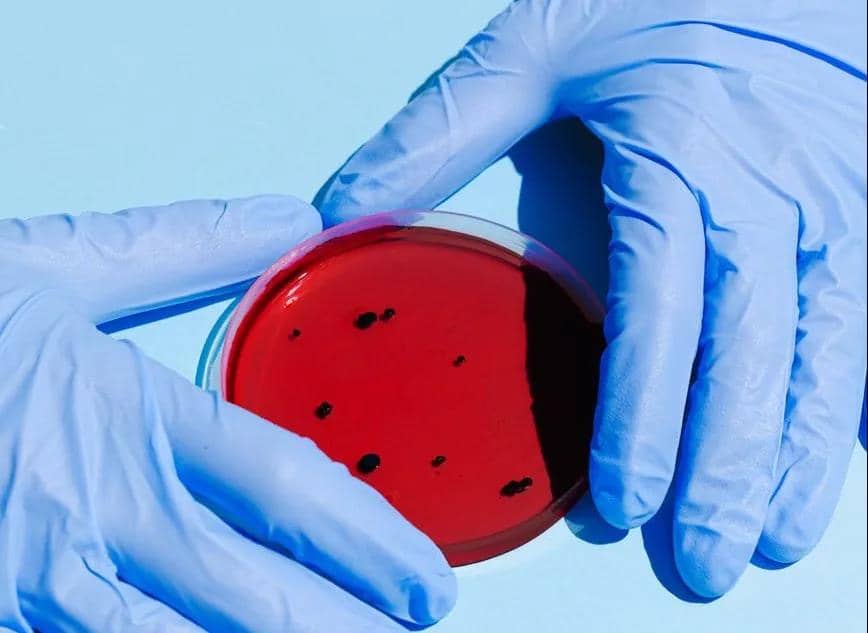

尿液很黄、异味重,怎么回事?出现这几种情况,是身体在报警
发布人:两渡河医院 发布时间:2020-04-08 10:24:57 阅读次数:1852
每个人天天都要排尿,但是大部分人排完尿就完事了,从来都没有观察过自己的尿液。可能大家会认为,尿液只是排泄物,排出来的都是身体的废物,没什么好观察的。其实,看似平平无奇的尿液,实则隐藏着很多我们不知道的“秘密”。

在尿液的成分里,含有最多的是水分,占比高于90%。除此之外,还含有少量的糖类、蛋白,以及尿酸等人体代谢物。每次小便时,我们闻到的一股怪味(臊味),其实是尿液中尿素等一些含氮物质的味道。尿液的颜色取决于尿色素的多少,而尿液中含有少量的尿黄素,受饮水量、食物的影响而呈现出或深或浅的颜色。所以,正常、健康的尿液是浅黄色的,且无沉淀物和浑浊的现象,就像沏的第一杯茶。尿液的颜色偶尔也会“变色”,如尿液变成透明色或无色。不过,这种情况大家不用过于担心,这是由于水喝多了。而汗出多了,尿液就会变得像啤酒的颜色,这也是正常的现象。

 不要以为尿液只会徘徊在无色与黄色之中,它也会像彩虹一样“五彩斑斓”,而不同的尿液颜色更是预示着不同的疾病。想知道我们的身体状况,看尿液的颜色是最直观的办法。一旦发现,尿液的颜色变得越来越深或是罕见的颜色,建议立即就医检查。这种颜色的尿液被称为“乳糜尿”,外观呈乳白色牛奶样,多见于丝虫病、腹腔淋巴管结核、肿瘤压迫胸导管等。当发现血液呈现褐黄色时,最常见的原因是身体缺水。尿液中的色素比例决定了尿液的颜色,当摄入的水分不足时,色素比例会增高,则尿液会呈现褐黄色。尿液偏橙色时,可能是尿路感染引起炎症,或是肝胆系统的疾病导致胆红素代谢紊乱。还有一种特殊的情况是,食物、药物代谢也会导致颜色发黄,如维生素b、胡萝卜。如果超过2周出现这种情况,最好是到医院泌尿科检查一下。出现淡红色尿液的可能性有很多种,例如尿血,也可能是肾病、肿瘤、尿道感染或前列腺疾病等问题的征兆,甚至可能是铅或汞中毒的表现。当然,也可能什么事也没,如果是吃了很多的甜菜、蓝莓、火龙果,尿液也有淡红色的可能!
不要以为尿液只会徘徊在无色与黄色之中,它也会像彩虹一样“五彩斑斓”,而不同的尿液颜色更是预示着不同的疾病。想知道我们的身体状况,看尿液的颜色是最直观的办法。一旦发现,尿液的颜色变得越来越深或是罕见的颜色,建议立即就医检查。这种颜色的尿液被称为“乳糜尿”,外观呈乳白色牛奶样,多见于丝虫病、腹腔淋巴管结核、肿瘤压迫胸导管等。当发现血液呈现褐黄色时,最常见的原因是身体缺水。尿液中的色素比例决定了尿液的颜色,当摄入的水分不足时,色素比例会增高,则尿液会呈现褐黄色。尿液偏橙色时,可能是尿路感染引起炎症,或是肝胆系统的疾病导致胆红素代谢紊乱。还有一种特殊的情况是,食物、药物代谢也会导致颜色发黄,如维生素b、胡萝卜。如果超过2周出现这种情况,最好是到医院泌尿科检查一下。出现淡红色尿液的可能性有很多种,例如尿血,也可能是肾病、肿瘤、尿道感染或前列腺疾病等问题的征兆,甚至可能是铅或汞中毒的表现。当然,也可能什么事也没,如果是吃了很多的甜菜、蓝莓、火龙果,尿液也有淡红色的可能!

一旦尿液呈现棕色,即与糖浆的颜色相近时,表明你的身体正在严重脱水的状态,必须要立即为身体补充水分。尿液与酱油色相近,是由于尿液中含有大量的游离血红蛋白。患有急性肾炎、急性黄疸型肝炎、肾脏挤压伤等患者,也会出现这种情况。有时睡醒起床,尿液会由于阵发性睡眠性血红蛋白尿病而呈现酱油色。蓝色或绿色的尿液是很少见的,正常的情况下是食物中含有的色素随尿液排出。另外,不排除是罕见的遗传病、细菌感染尿路引起的。曾经有一位高龄女患者,长期留置尿管,检查出尿菌,出现了紫红色的尿液。这种紫红色的尿液一般是因为使用了导尿管而发生尿路感染,在细菌的作用下,尿液就呈现这种颜色。


如果无法从尿液的颜色判断清楚身体的情况,那么我们还可以从尿液的气味、排尿量、排尿次数等进行更进一步的判断。正常的尿液是没有刺激性气味的,只有出现异常时,才会散发出异味。如果闻到尿液的气味出现以下奇怪的味道,那就得重视起来了。每个人排尿量的范围一般都是大同小异的。如果某一天,你突然发现自己的排尿量发生了明显的改变,或者是夜尿增多了,那就要考虑是不是肾出了问题。标准:正常人的尿量约1000~2000ml/天(相当于2~4瓶矿泉水)。排尿量多于2500ml/天,则属于多尿;少于400ml/天,则属于少尿。

正常的排尿次数是——白天约排尿4~8次,夜间是0~1次。直至今天,还会有不少朋友认为,排尿次数多,肯定是肾出了问题!其实并非如此。饮水过多或喝了茶、咖啡,也会增加排尿的次数。如果排尿次数多于8次/天,且伴有尿痛等症状,那就需要考虑是不是泌尿系统感染。
小口小口地喝水,每次喝水的间隔时间不超过2小时,就能完美解决尿意频繁的问题了;而茶和咖啡还是少喝为妙!
尿液的异常与饮食、日常习惯、卫生清洁息息相关,保持良好的生活方式才是“王道”。如果你担心尿液发黄、气泡过多的问题,建议还是去医院检查清楚最安心!
温馨提示:本平台分享健康图文信息,仅供大家参考,不作为医疗诊断依据。如有需要,请在医师指导下使用。[版权归原作者所有,如涉侵权,请联系删除。]